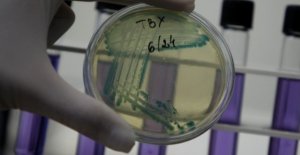

CIK
Danas ponovni izbori u jedinicama Istočni Drvar i ... Ponovni izbori za načelnike i skupštine općina u izbornim jedinicama Istočni Drvar i Istočni Mostar na redovnim biračkim mjestima 058B001 i 158B001 te u izbornoj jedinici Vukosavlje na redovnom biračkom mjestu 018B005 bit će održani u nedjelju, 18. novembra
Danas ponovni izbori u jedinicama Istočni Drvar i ... Ponovni izbori za načelnike i skupštine općina u izbornim jedinicama Istočni Drvar i Istočni Mostar na redovnim biračkim mjestima 058B001 i 158B001 te u izbornoj jedinici Vukosavlje na redovnom biračkom mjestu 018B005 bit će održani u nedjelju, 18. novembra